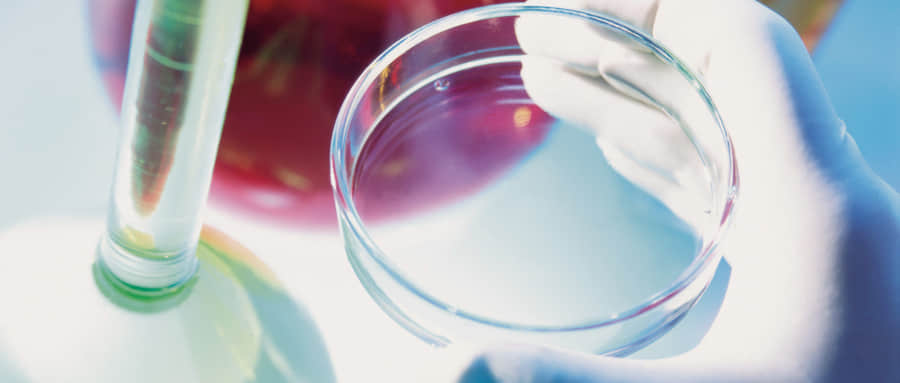

对于一些分数没有达到本科线的同学们来说,如何选择一所好一点的专科院校就尤其重要的。虽然没有入读一所本科院校,但只要选好学校和专业,努力学习,继续深造,专科生也可以成为顶尖人才。那么,本期93高考网小编就以安徽省为例,为大家列出安徽省在专科批次招生的大学前十强,并为大家挑选出在安徽专科批次招生的最好大学,供2021届高考生参考。

一、安徽专科批次招生的大学前十强
对于每个省大学的排名,每个人都有不同的看法。那么本期小编就结合GDI高职高专榜和各校在2020年的最低招生位次来给大家排列出安徽前十的大专院校。
以下是以安徽省教育考试院公布的数据进行整理的。
安徽省专科批次招生大学2020年最好位次排名前十(理)

安徽省专科批次招生大学2020年最好位次排名前十(文)

在2020年GDI排名(安徽)中,排在前十位的高职院校是:
GDI高职高专排行是广州日报数据和数字化研究院推出的一个以职场竞争力指数、教育竞争力指数、品牌竞争力指数和二次评估指数为指标推出的一个我国专科院校的榜单
以上用到了位次排名,而没有用分数线排名,是因为每个高校的录取分数线每年都不一样,有时会出现较大的波动,但院校的位次排名相比来说更稳定些,参考的价值更大。
有一点需要注意的是,在位次排名中,不全是高职院校,还有一些本科院校,只是这些院校也在专科批次中招生,所以也列入到其中进行了排名。这些院校相比高职院校有几个优点:
一是学校级别更好,本科院校在各方面来说都要比专科院校好。二是教育资源更好,本科院校拥有比专科院校更好的生活环境,实验室、图书馆、实习实训基地、就业资源等,虽然是以专科生入读,但在同一所学校里,学生能够使用的资源是同等的。三是学习氛围好,因为本科院校的学生大多数会进行考研,这也导致学校的学习氛围更浓。

二、安徽省专科批次招生的最好大学
小编认为,要判定一所大学是否是好的大学,需要从多角度去分析,如所处的地理位置、教师力量、生源质量等。所以小编就从这几方面为大家筛选出了在安徽专科批次招生最好的大学——安徽工业大学。当然芜湖职业技术学院是安徽高职院校里面最好的。
那么安徽工业大学为什么是安徽专科批次招生的最好大学呢?下面小编就从地理位置、教师力量、生源质量、王牌专业为大家分析一下安徽工业大学。
地理位置:安徽工业大学所在的位置是安徽省马鞍山,该城市是皖江经济带的核心城市之一以及新兴移民城市、皖南国际旅游文化示范区重要节点城市。所以从地理位置来说还是比较好的。
教师力量:设有17个教学院部,71个本科招生专业,17个一级学科硕士点,8个专业学位类别,21个专业学位授权点,2个一级学科博士点,1个博士后科研流动站。现有教职工2029人,其中,正高级职称222人、副高级职称465人,具有博士学位教师597人。全日制本科生21749人,各类研究生2792人,留学生380人,宝钢大专班学生211人,各类继续教育在籍学生5286人。该校共有49个硕士点、2个博士点、16个特色专业。
生源质量:从生源质量来看,该所院校主要是在本科批次中招生。虽然好的生源不一定能培养出好的优秀人才,但有了好的生源,才可能会培养出更强的人才。
学校王牌专业:该所院校有2个教育部评估的一级学科C+级——材料科学与工程、化学工程与技术
以上就是本期的内容,相信同学们看到这里,对于“安徽省排名前十的专科学校”已经有所了解,最后,祝愿同学们都能早日圆梦大学。
责任编辑:晶晶























 5245
5245

 被折叠的 条评论
为什么被折叠?
被折叠的 条评论
为什么被折叠?








